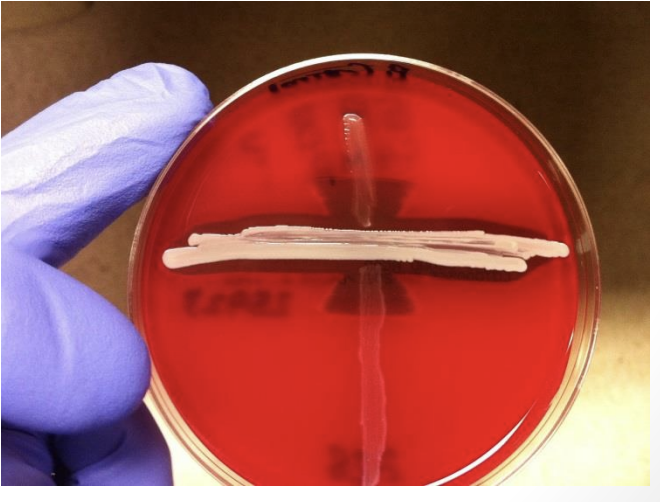

Strep Pyogenes Group A Strep key features:
+ for:
virulence factor:
(PYR) positive
M protein virulence factor • Inhibits phagocytosis
Strep Pyogenes Group A Strep causes 3 categories of illness
- ) (2)
- ) (3)
- ) (2)
Infections
Pharyngitis (Strep throat) • Skin: Cellulitis/Impetigo
Toxin-mediated disease
Scarlet fever • Necrotizing fasciitis • Toxic Shock Syndrome
Immune disease
Rheumatic fever • Post-strep glomerulonephritis
Strep Pharyngitis:
Important to identify and treat S. pyogenes Pharyngitis because:
Diagnosis:
Treatment::
Prevent rheumatic fever
-15-30% pharyngitis due to S. pyogenes • (Many cases viral)
Diagnosis: • Throat culture • Rapid antigen test (useful if positive)
Treatment: Penicillin, amoxicillin, cephalosporins
S. Pyogenes Skin Infections:
Cellulitis and Impetigo (“honey-crusted”)
Both commonly caused by Strep but also S. Aureus •
Antibiotics need to cover Strep and Staph

Scarlet Fever
follows:
reaction to:
symptoms:
classic finding:
Rash following pharyngitis
Skin reaction to erythrogenic toxin
Gene for toxin transferred by lysogenic phage
Fever, sore throat, diffuse red rash-many small papules (“sandpaper” skin) • Starts head/neck →expands to cover trunk
Classic finding: Strawberry tongue • Eventually skin desquamates • (Palms and soles are usually spared)

2 types of Necrotizing Fasciitis & classic case
Type 1:
Polymicrobial • Often anaerobes (Bacteroides, Clostridium, etc.) • Occurs in diabetics, immunocompromised, post surgery
Type 2:
Group A strep (sometimes Staph) • Occurs in otherwise healthy people after skin injury
Classic case:
Minor skin trauma • Redness/warmth (can be confused with cellulitis) • Pain out of proportion!!! to exam • Fever, hypotension
Rheumatic Fever
follows:
causes:
3 signs:
Follows group A strep pharyngitis infection
Streptococcus infection→ anti-strep antibodies which Cross react with tissue antigens
1.)Aschoff bodies
Cardiac nodules with inflammatory cells (granulomas) • Pathognomonic for rheumatic carditis
2.)Anitschkow’s cells
Macrophages with owl eye appearance
3.)Elevated ASO titers
how to diagnose rheumatic fever:
2 major or 1 major & 2 minor

Rheumatic Fever
clues
treatment
cardiac involvement
Clues:
Sore throat or URI followed by joint pain, new murmur
Treatment: Penicillin
Cardiac involvement
• Acute RF → severe valve disease, heart failure • Later (after recovery) → mitral stenosis (rarely aortic or tricuspid valves)
Post-streptococcal GN
• Nephritic syndrome 2-3 weeks after GAS infection
Strep Agalactiae Group B Strep
2 important features
Makes CAMP factor
Staph Aureus makes β-hemolysin • CAMP factor enhances lysis by β-hemolysis
Hydrolyzes the compound hippurate • Will alter color of hippurate test
Strep Agalactiae Group B Strep
colonizes:
importance in pregnancy:
Colonizes vagina • Causes infections in newborns • Babies infected in utero or during birth • & therefore a common cause of Pneumonia, meningitis, sepsis in babies
Pregnant women screened 35-37 weeks, Women GBS (+) receive prophylaxis • Four hours prior to delivery
Penicillin, ampicillin, or cefazoli
Strep Pneumonia
_ shape
key virulence factor
“Lancet shaped” gram (+) cocci •
IgA protease •
Key virulence factor: Polysaccharide capsule • Prevents phagocytosis • Basis of vaccine from capsular material • Asplenic patients at risk for sepsis • Splenectomy • Sickle cell anemia
Strep Pneumonia causes:
• Lobar Pneumonia • Meningitis • Otitis Media • Sinusitis
Viridans Group Strep
colonizes and therefore causes:
also causes subacute:
Normal mouth flora • Cause dental carries (Strep Mutans) •
SUBACUTE endocarditis (Strep Sanguis) • Slow onset symptoms; less sick patient • Often affects ABNORMAL valves(not as virulent as staph) • Dextran → fibrin • Requires endothelial damage • Mitral valve prolapse • Pearl: Recent dental procedure
Enterococcus
colonizes;
infections caused:
resistant to:
best treatment:
• Normal colonic bacteria
Infections: • UTIs • Endocarditis (rare)
Resistant to penicillin • Vancomycin resistant enterococcus (VRE)
synergistic therapy • Vancomycin/gentamycin • Ampicillin/gentamycin
(Relatively resistant to cell wall agents • Penicillin, ampicillin, and vancomycin • Impermeable to aminoglycosides)
Enterococcus UTIs
• Often hospital acquired, associated with catheters • Removal of catheter alone may cure infection • Urinalysis: NEGATIVE for nitrites like staph
Enterococcus Endocarditis
Rare cause of:
Usually after :
__often used for empiric therapy before culture data available
___ effect of __ antibiotics
Rare cause of endocarditis
Usually after manipulation GU tract • TURP procedure, cystoscopy
Vancomycin/gentamycin often used for empiric therapy before culture data available
Synergistic effect of dual antibiotics
Strep Bovis
Normal _
Rare cause _
Strongly associated with_
Normal colonic bacteria
Rare cause bacteremia/endocarditis
Strongly associated with colon cancer


